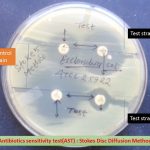
Stokes disc diffusion method
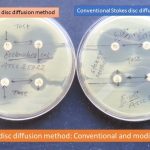
Stokes disc diffusion method conventional and modified

Collection Group: Clinical Bacteriology
Stokes Disc Diffusion Method: Introduction, Principle, Procedure and Result Interpretation
Introduction of Stokes Disc Diffusion Method Stokes disc diffusion method...
Introduction of Stokes Disc Diffusion Method Stokes disc diffusion method...
Stokes Method: Introduction,Types, Principle, Procedure and Result Interpretation
Introduction of Stokes Disc Diffusion Method Stokes disc diffusion method...
Introduction of Stokes Disc Diffusion Method Stokes disc diffusion method...
Shigella: Introduction, Morphology, Culture Characteristics, Pathogenesis, Lab Diagnosis and Treatment
 Introduction of Shigella Shigella are bacteria and causing an infectious...
Introduction of Shigella Shigella are bacteria and causing an infectious...
